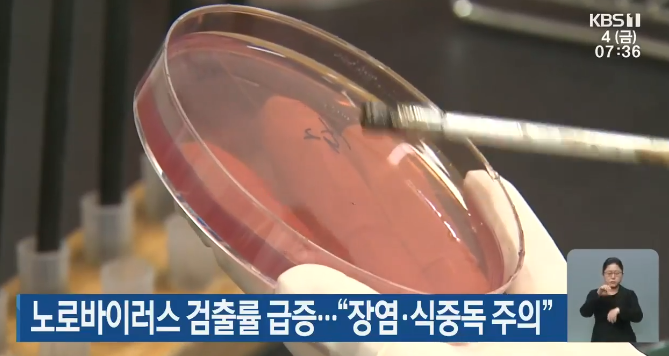

노로바이러스 장염 증상, 치료 및 예방법
안녕하세요. 오늘은 노로바이러스 장염 증상, 치료 및 예방법에 대해 소개해 드리겠습니다.
식중독은 언제 많이 발생 할까요? 맞습니다. 여름철입니다.
하지만 최근 식중도 발생 빈도수가 겨울철에도 높다고 합니다.
겨울철에 발생하는 식중독 대부분 노로바이러스가 원인이라고 합니다.

얼마 전 친구랑 오랜만에 만나서 스트레스도 풀 겸 회와 같이 굴찜, 생굴을 먹었는데 저는 별 이상이 없었지만 친구는 노로바이러스로 인한 장염증상으로 고생했다고 합니다.
정확한 원인은 굴인지 모르지만 의심은 가더라고요.
목차
노로바이러스란?
노로바이러스 원인, 감염경로
노로바이러스 장염 증상 및 예방법
식중독 노로바이러스(Norrovirus)란?
노로바이러스 감염증은 사람의 위와 장에 염증을 일으키는 유행성 바이러스성 위장염으로, 연령, 남녀노소와 상관없이 감염되며 겨울철인 그해 12월부터 다음 해 1~2월 주로 발생하며 생존력이 뛰어나 냉동(20 ºC), 냉장된 상태로 죽지 않고, 50˚이상 30분 가열 시도 생존해 감염이 된다고 합니다.
또한 기존 식중독 바이러스들과는 다르게 추운 날씨에 움직임 활발해서 요즘처럼 찬바람이 불면 더 극성을 부립니다.
얼마 전 통영, 거제, 고성에서 채취된 굴에서 노로바이러스가 검출되어 당분간 섭취 시 익혀 드시기 바랍니다.
노로바이러스 원인, 감염경로

바이러스에 걸리는 원인 여러 가지이지만 주된 원인은 생굴, 젓갈, 상하거나 오염된 어폐류를 익히지 않고 먹었을 때 감염되는 수인성, 식품 매개 질환으로 음식을 조리한 사람의 손, 침등으로 요리된 음식을 먹었을 때, 감염된 사람과 접촉을 통해 감염됩니다. 그러므로 바이러스 증상이 나타난 사람과는 접촉을 피하고, 사용된 물건 등을 만지면 안 됩니다.
예를 들면 환자가 일상생활에서 만진 문, 화장실 변기, 수도꼭지 등 본인의 입이나 음식물을 섭취할 경우에도 전염된다고 합니다.



*소량으로도 감염이 되므로 주의하시면 좋겠습니다.
노로바이러스 장염 증상

증상
12~48시간 이후 잠복기가 지난 후 나오는데요. 그 증상을 보면 발열, 설사, 복통, 탈수, 메스꺼움 등이 심하며, 소아 같은 경우 구토 증상이 보이며 대부분의 성인은 설사 증상이 흔하다고 합니다.
치료방법
초기 증상을 잘 보시고 병원 방문 치료하시면 더 좋겠죠.
어린이, 노인 같이 면역력이 약한 분들은 탈수가 심하면 안 좋으므로 치료를 받으시면 좋습니다.
성인인 경우 대부분 24~60시간 지속되다 저절로 회복된다고 하지만 설사가 심하면 체력을 유지하기 위해 죽, 보리차 이온음료 등을 드시면 탈수방지 및 전해질을 체내에 공급해 치료를 할 수 있습니다.
노로바이러스 예방법

백신이나 항바이러스 예방 접종 백신이 없으므로 청결 및 익힌 음식을 드시게 최선입니다.
감염경로가 주로 일상생활에서 나오므로 외출 후, 요리 전, 식사 전, 화장실 사용 후에 꼭 손 씻기를 하시고
채소, 과일을 깨끗이 세척 후, 굴이나 어폐류는 익혀 드시면 가능합니다.
또한 요리 시에는 100˚C 이상 1분 가열, 70˚도 5분 이상 가열 충분히 익힌 면 바이러스가 사멸되므로 익혀 드세요.


지하수나 수돗물, 약수 등을 식용수로 마시는 분들은 끓여 드시면 예방 가능합니다.
바이러스 감염자가 있다면 옷은 즉시 세탁, 소독제로 살균하시면 됩니다.


모유수유 중 노로바이러스 감염되면 모유로 통한 감염은 안되지만 신체 및 손 옷 등으로 감염될 수도 있으니 수유 전에 손, 옷을 깨끗이 씻은 후 수유하시면 된다고 합니다.
카카오TV 겨울철 식중독 : tv.kakao.com/v/404662978
생굴을 좋아하시는 분들은 소금물에 10분 정도 담그신 후 생굴을 씻어 레몬즙을 뿌려 드시면 좋습니다.
*레몬즙 성분인 시트르산이 감염력을 낮추는 효과가 있다고 합니다.
도움이 되는 글:
오늘은 노로바이러스 장염 증상, 원인, 예방법에 대해서 알아봤습니다.
건강한 하루 보내시기 바랍니다.
'슬기로운 생활정보' 카테고리의 다른 글
| 2021년 최저임금 월 실수령액 총정리 (0) | 2020.12.23 |
|---|---|
| 청년 주거급여 분리지급 신청자격 및 신청서류 총정리 (0) | 2020.12.21 |
| 겨울철 실내 적정 건강온도, 건강습도 (0) | 2020.12.09 |